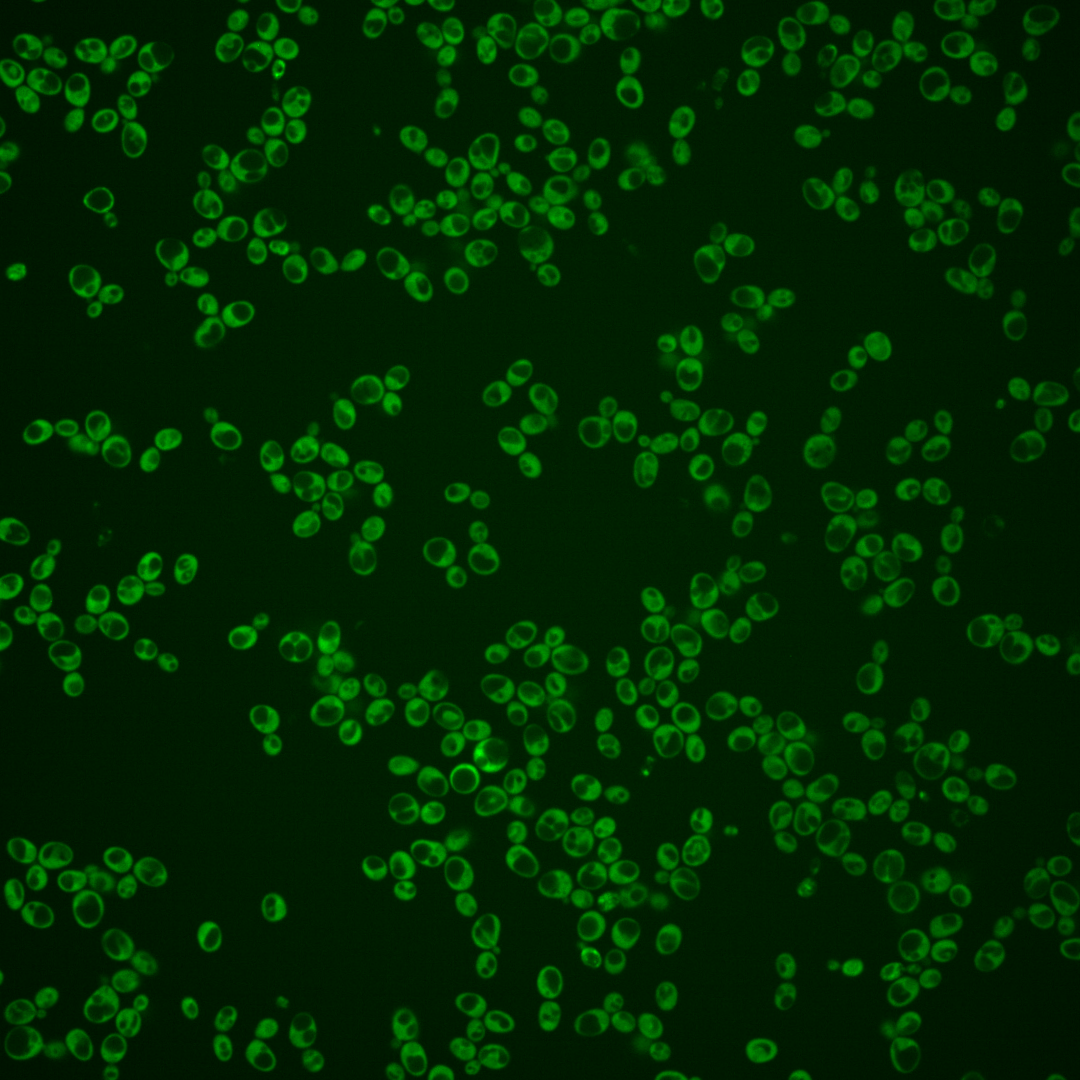
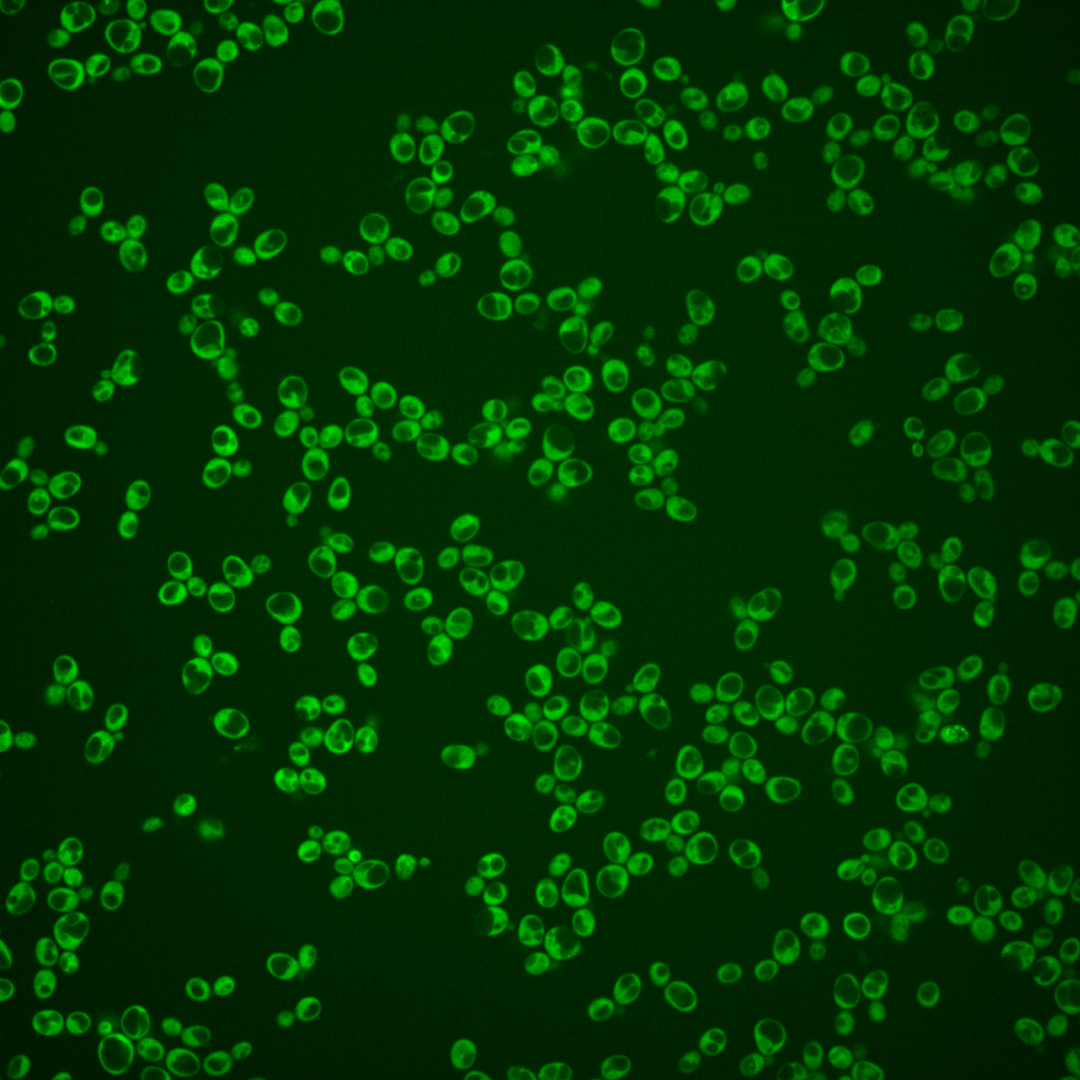
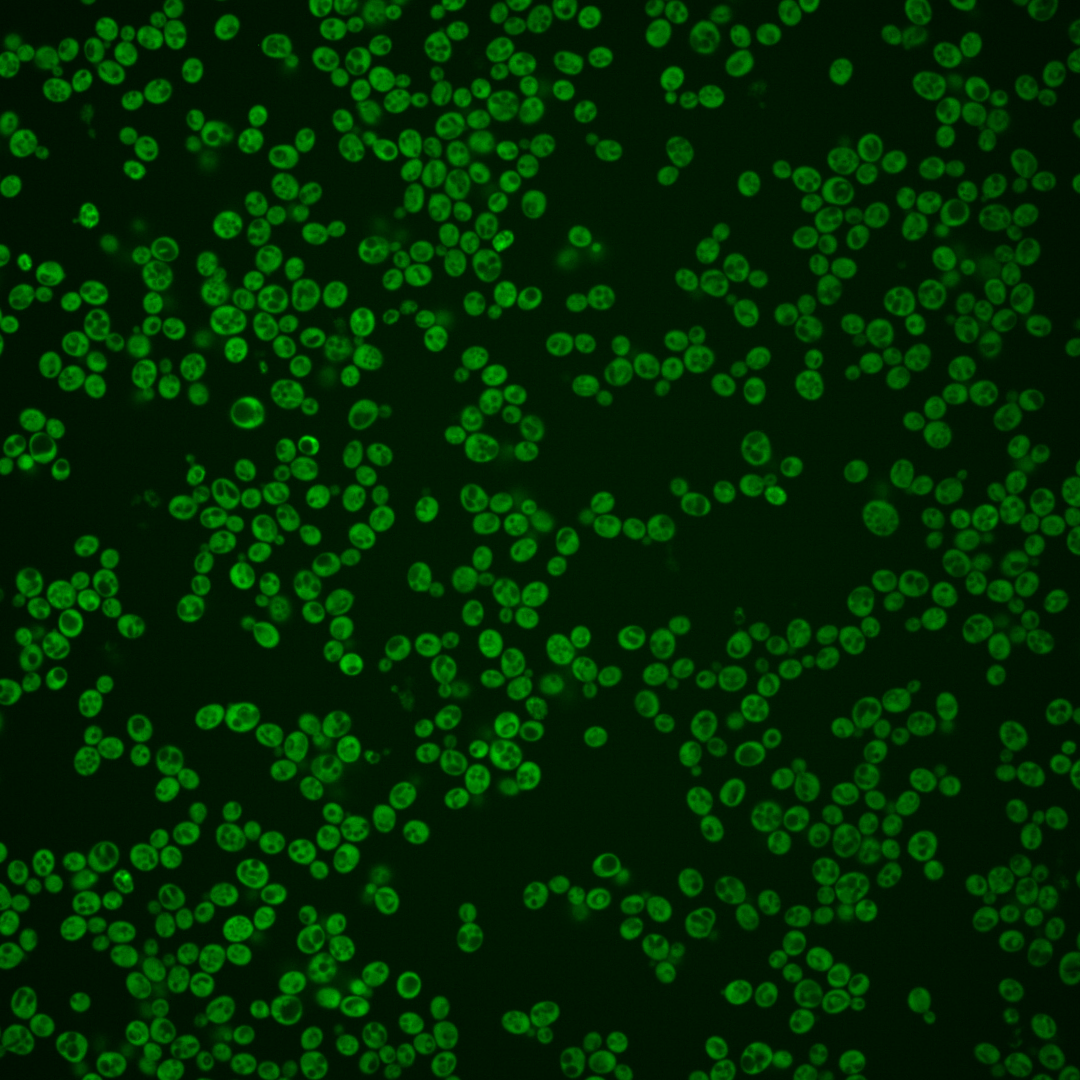
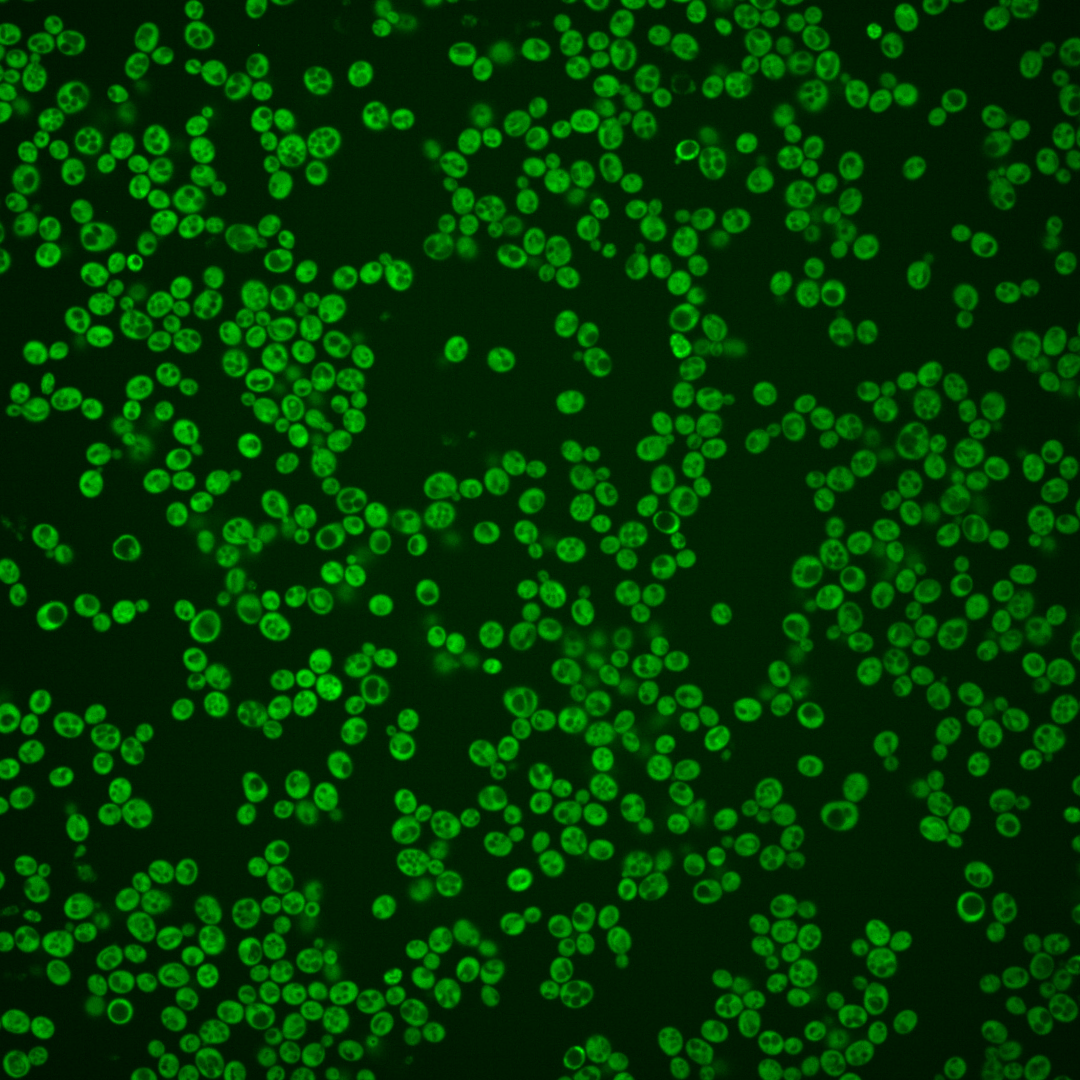
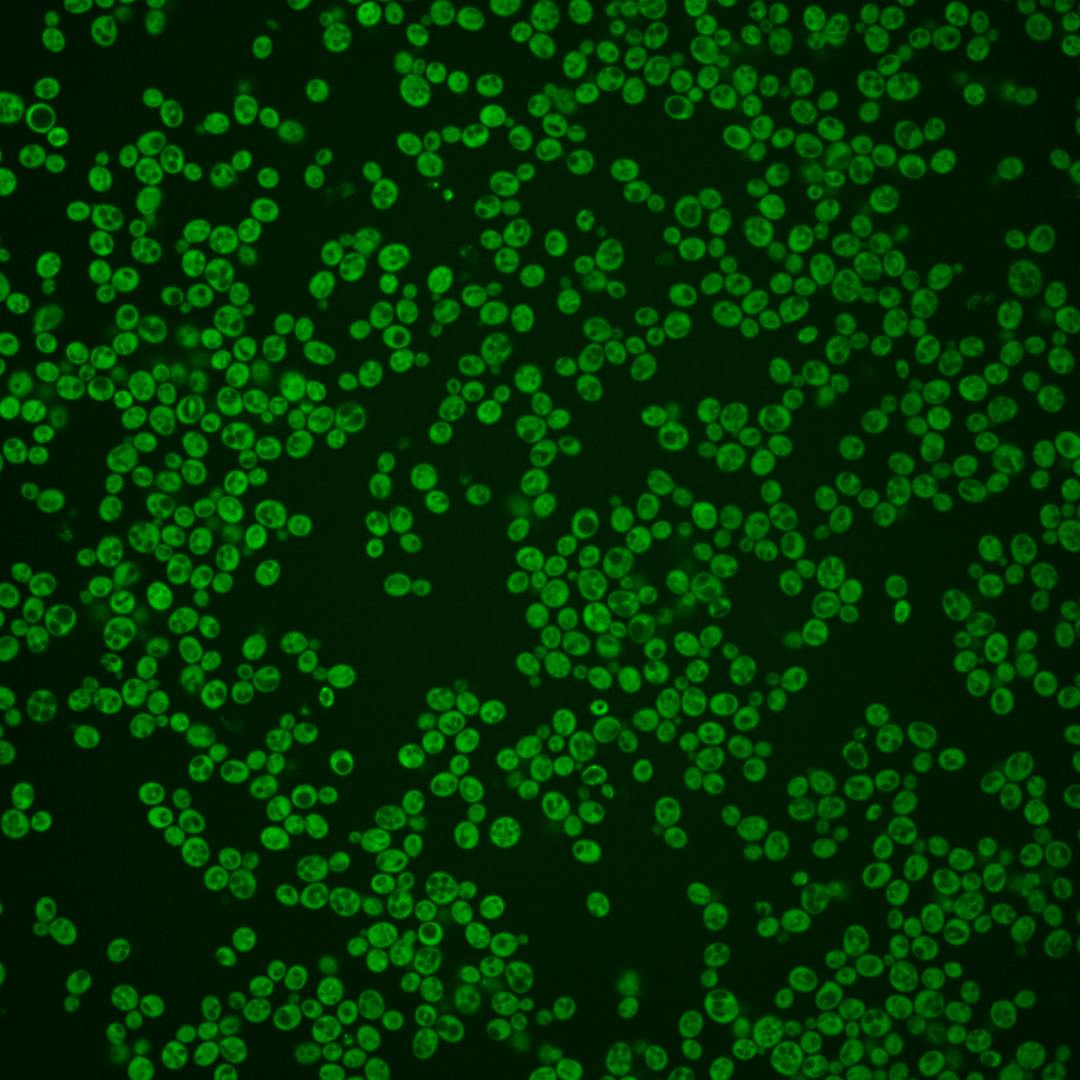
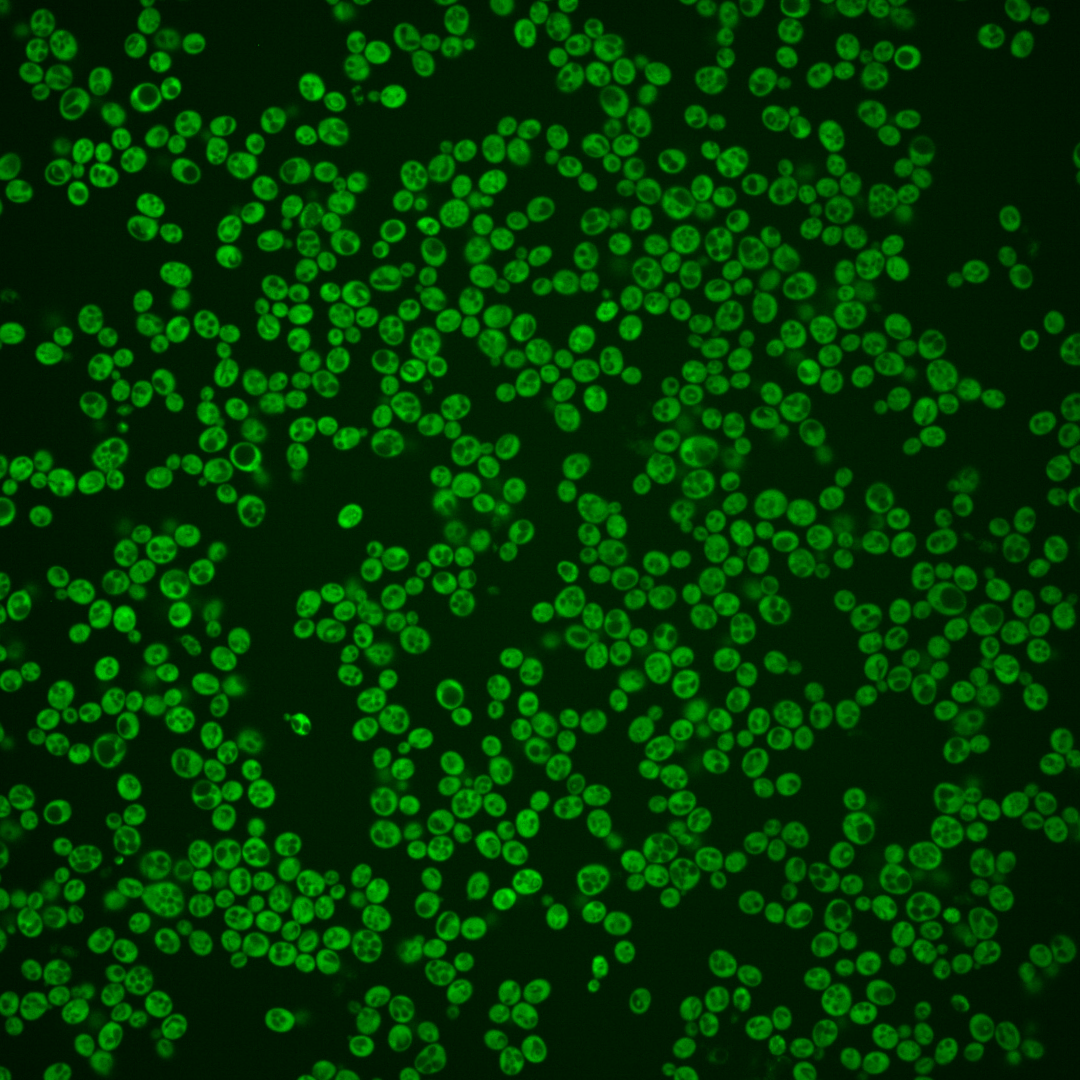

| Standard name | |
|---|---|
| Human Ortholog | |
| Description | Nitrogen catabolite repression transcriptional regulator; inhibits GLN3 transcription in good nitrogen source; role in sequestering Gln3p and Gat1p to the cytoplasm; has glutathione peroxidase activity and can mutate to acquire GST activity; self-assembly under limited nitrogen conditions creates [URE3] prion and releases catabolite repression |
Micrographs




















































































Sub-cellular Localization
Yeast GFP Assignment
Protein Abundance
Localization Change
External localization resources
| ensLOC | DeepLoc | |||||||||||||||||||||||
|---|---|---|---|---|---|---|---|---|---|---|---|---|---|---|---|---|---|---|---|---|---|---|---|---|
| Localization | WT1 | WT2 | WT3 | RAP60 | RAP140 | RAP220 | RAP300 | RAP380 | RAP460 | RAP540 | RAP620 | RAP700 | HU80 | HU120 | HU160 | rpd3Δ_1 | rpd3Δ_2 | rpd3Δ_3 | WT1 | WT2 | WT3 | AF100 | AF140 | AF180 |
| Cortical Patches | 0 | 0 | 0 | 1 | 3 | 0 | 5 | 6 | 6 | 4 | 4 | 11 | 0 | 0 | 1 | 1 | 0 | 4 | 0 | 0 | 2 | 0 | 0 | 1 |
| Bud | 0 | 0 | 0 | 0 | 0 | 0 | 0 | 5 | 1 | 3 | 6 | 4 | 0 | 0 | 0 | 0 | 0 | 1 | 0 | 0 | 0 | 0 | 0 | 1 |
| Bud Neck | 0 | 0 | 0 | 0 | 0 | 0 | 0 | 0 | 0 | 0 | 0 | 0 | 0 | 0 | 0 | 0 | 0 | 0 | 0 | 1 | 0 | 0 | 0 | 0 |
| Bud Site | 0 | 0 | 0 | 0 | 0 | 0 | 0 | 0 | 0 | 0 | 0 | 0 | 0 | 0 | 0 | 0 | 0 | 0 | – | – | – | – | – | – |
| Cell Periphery | 1 | 10 | 11 | 10 | 14 | 11 | 10 | 20 | 7 | 8 | 15 | 20 | 3 | 7 | 15 | 43 | 29 | 49 | 0 | 0 | 1 | 2 | 0 | 1 |
| Cytoplasm | 104 | 329 | 237 | 180 | 279 | 162 | 179 | 224 | 146 | 111 | 203 | 193 | 222 | 223 | 255 | 364 | 354 | 442 | 120 | 328 | 230 | 155 | 285 | 291 |
| Endoplasmic Reticulum | 0 | 9 | 5 | 7 | 24 | 9 | 11 | 21 | 10 | 5 | 20 | 18 | 4 | 3 | 7 | 13 | 13 | 17 | 2 | 8 | 9 | 10 | 16 | 11 |
| Endosome | 0 | 0 | 0 | 0 | 0 | 0 | 0 | 1 | 0 | 0 | 0 | 0 | 0 | 0 | 0 | 0 | 0 | 0 | 0 | 2 | 0 | 0 | 0 | 0 |
| Golgi | 0 | 0 | 0 | 0 | 2 | 1 | 0 | 1 | 0 | 0 | 0 | 0 | 0 | 2 | 1 | 2 | 2 | 1 | 0 | 1 | 0 | 1 | 1 | 1 |
| Mitochondria | 2 | 3 | 0 | 5 | 10 | 21 | 66 | 53 | 47 | 64 | 107 | 56 | 0 | 0 | 0 | 4 | 9 | 18 | 0 | 2 | 2 | 4 | 1 | 5 |
| Nucleus | 0 | 0 | 2 | 1 | 2 | 0 | 4 | 0 | 3 | 3 | 1 | 1 | 0 | 1 | 1 | 2 | 5 | 5 | 0 | 0 | 0 | 2 | 0 | 0 |
| Nuclear Periphery | 0 | 0 | 0 | 0 | 0 | 0 | 0 | 0 | 2 | 2 | 0 | 1 | 0 | 0 | 0 | 0 | 0 | 1 | 0 | 1 | 1 | 0 | 0 | 0 |
| Nucleolus | 0 | 0 | 0 | 0 | 0 | 0 | 0 | 0 | 0 | 0 | 0 | 0 | 0 | 0 | 0 | 0 | 0 | 0 | 0 | 0 | 0 | 0 | 0 | 0 |
| Peroxisomes | 0 | 0 | 0 | 0 | 0 | 0 | 0 | 0 | 0 | 0 | 0 | 0 | 0 | 0 | 0 | 0 | 0 | 0 | 0 | 0 | 0 | 0 | 0 | 0 |
| SpindlePole | 0 | 0 | 0 | 0 | 0 | 0 | 0 | 0 | 0 | 0 | 0 | 0 | 0 | 0 | 0 | 0 | 0 | 0 | 0 | 0 | 0 | 0 | 0 | 0 |
| Vac/Vac Membrane | 1 | 2 | 2 | 4 | 8 | 7 | 11 | 22 | 2 | 10 | 13 | 13 | 4 | 0 | 0 | 56 | 47 | 35 | 0 | 5 | 5 | 3 | 8 | 6 |
| Unique Cell Count | 106 | 343 | 244 | 191 | 323 | 194 | 249 | 312 | 197 | 176 | 319 | 281 | 229 | 226 | 265 | 434 | 414 | 508 | 128 | 354 | 254 | 182 | 320 | 326 |
| Labelled Cell Count | 108 | 353 | 257 | 208 | 342 | 211 | 286 | 353 | 224 | 210 | 369 | 317 | 233 | 236 | 280 | 485 | 459 | 573 | 128 | 354 | 254 | 182 | 320 | 326 |
Yeast GFP Assignment
Protein Abundance
| Screen | WT1 | WT2 | WT3 | RAP60 | RAP140 | RAP220 | RAP300 | RAP380 | RAP460 | RAP540 | RAP620 | RAP700 | HU80 | HU120 | HU160 | rpd3Δ_1 | rpd3Δ_2 | rpd3Δ_3 | AF100 | AF140 | AF180 |
|---|---|---|---|---|---|---|---|---|---|---|---|---|---|---|---|---|---|---|---|---|---|
| Mean Cell GFP Intensity (1e-4) | 10.5 | 14.2 | 11.7 | 10.6 | 10.3 | 8.9 | 7.7 | 8.7 | 7.4 | 7.4 | 7.3 | 8.0 | 11.2 | 12.2 | 12.1 | 16.1 | 15.7 | 15.9 | 12.1 | 12.4 | 13.7 |
| Std Deviation (1e-4) | 1.5 | 2.3 | 1.8 | 1.7 | 1.7 | 2.1 | 1.7 | 1.7 | 1.4 | 1.6 | 1.5 | 2.0 | 1.9 | 1.8 | 2.0 | 4.8 | 5.0 | 4.9 | 2.1 | 2.2 | 2.5 |
| Intensity Change (Log2) | – | – | – | -0.14 | -0.18 | -0.38 | -0.59 | -0.43 | -0.66 | -0.66 | -0.68 | -0.54 | -0.06 | 0.07 | 0.06 | 0.47 | 0.43 | 0.45 | 0.05 | 0.09 | 0.23 |
Localization Change
| Localization | RAP60 | RAP140 | RAP220 | RAP300 | RAP380 | RAP460 | RAP540 | RAP620 | RAP700 | HU80 | HU120 | HU160 | rpd3Δ_1 | rpd3Δ_2 | rpd3Δ_3 |
|---|---|---|---|---|---|---|---|---|---|---|---|---|---|---|---|
| Cortical Patches | 0 | 0 | 0 | 0 | 0 | 0 | 0 | 0 | 3.1 | 0 | 0 | 0 | 0 | 0 | 0 |
| Bud | 0 | 0 | 0 | 0 | 0 | 0 | 0 | 0 | 0 | 0 | 0 | 0 | 0 | 0 | 0 |
| Bud Neck | 0 | 0 | 0 | 0 | 0 | 0 | 0 | 0 | 0 | 0 | 0 | 0 | 0 | 0 | 0 |
| Bud Site | 0 | 0 | 0 | 0 | 0 | 0 | 0 | 0 | 0 | 0 | 0 | 0 | 0 | 0 | 0 |
| Cell Periphery | 0.4 | -0.1 | 0.6 | -0.3 | 1.0 | -0.5 | 0 | 0.1 | 1.3 | -2.1 | -0.8 | 0.6 | 2.5 | 1.3 | 2.4 |
| Cytoplasm | -1.5 | -4.4 | -5.0 | -7.7 | -7.9 | -7.1 | -9.1 | -9.5 | -8.4 | -0.1 | 1.2 | -0.6 | -5.2 | -4.8 | -4.4 |
| Endoplasmic Reticulum | 1.0 | 2.9 | 1.5 | 1.5 | 2.6 | 1.7 | 0 | 2.4 | 2.4 | 0 | 0 | 0.4 | 0.7 | 0.8 | 1.0 |
| Endosome | 0 | 0 | 0 | 0 | 0 | 0 | 0 | 0 | 0 | 0 | 0 | 0 | 0 | 0 | 0 |
| Golgi | 0 | 0 | 0 | 0 | 0 | 0 | 0 | 0 | 0 | 0 | 0 | 0 | 0 | 0 | 0 |
| Mitochondria | 0 | 0 | 5.3 | 8.6 | 6.8 | 8.1 | 10.2 | 10.1 | 7.4 | 0 | 0 | 0 | 0 | 0 | 3.0 |
| Nucleus | 0 | 0 | 0 | 0 | 0 | 0 | 0 | 0 | 0 | 0 | 0 | 0 | 0 | 0 | 0 |
| Nuclear Periphery | 0 | 0 | 0 | 0 | 0 | 0 | 0 | 0 | 0 | 0 | 0 | 0 | 0 | 0 | 0 |
| Nucleolus | 0 | 0 | 0 | 0 | 0 | 0 | 0 | 0 | 0 | 0 | 0 | 0 | 0 | 0 | 0 |
| Peroxisomes | 0 | 0 | 0 | 0 | 0 | 0 | 0 | 0 | 0 | 0 | 0 | 0 | 0 | 0 | 0 |
| SpindlePole | 0 | 0 | 0 | 0 | 0 | 0 | 0 | 0 | 0 | 0 | 0 | 0 | 0 | 0 | 0 |
| Vacuole | 0 | 0 | 0 | 2.5 | 3.6 | 0 | 3.0 | 2.4 | 2.6 | 0 | 0 | 0 | 5.4 | 5.0 | 3.6 |
External localization resources
Images






























Protein Concentration and Protein Localization Data
| R1 | R2 | R3 | ||||||||||||||||
|---|---|---|---|---|---|---|---|---|---|---|---|---|---|---|---|---|---|---|
| G1 Pre-START | G1 Post-START | S/G2 | Metaphase | Anaphase | Telophase | G1 Pre-START | G1 Post-START | S/G2 | Metaphase | Anaphase | Telophase | G1 Pre-START | G1 Post-START | S/G2 | Metaphase | Anaphase | Telophase | |
| Concentration | – | – | – | – | – | – | – | – | – | – | – | – | – | – | – | – | – | – |
| Actin | – | – | – | – | – | – | – | – | – | – | – | – | – | – | – | – | – | – |
| Bud | – | – | – | – | – | – | – | – | – | – | – | – | – | – | – | – | – | – |
| Bud Neck | – | – | – | – | – | – | – | – | – | – | – | – | – | – | – | – | – | – |
| Bud Periphery | – | – | – | – | – | – | – | – | – | – | – | – | – | – | – | – | – | – |
| Bud Site | – | – | – | – | – | – | – | – | – | – | – | – | – | – | – | – | – | – |
| Cell Periphery | – | – | – | – | – | – | – | – | – | – | – | – | – | – | – | – | – | – |
| Cytoplasm | – | – | – | – | – | – | – | – | – | – | – | – | – | – | – | – | – | – |
| Cytoplasmic Foci | – | – | – | – | – | – | – | – | – | – | – | – | – | – | – | – | – | – |
| Eisosomes | – | – | – | – | – | – | – | – | – | – | – | – | – | – | – | – | – | – |
| Endoplasmic Reticulum | – | – | – | – | – | – | – | – | – | – | – | – | – | – | – | – | – | – |
| Endosome | – | – | – | – | – | – | – | – | – | – | – | – | – | – | – | – | – | – |
| Golgi | – | – | – | – | – | – | – | – | – | – | – | – | – | – | – | – | – | – |
| Lipid Particles | – | – | – | – | – | – | – | – | – | – | – | – | – | – | – | – | – | – |
| Mitochondria | – | – | – | – | – | – | – | – | – | – | – | – | – | – | – | – | – | – |
| None | – | – | – | – | – | – | – | – | – | – | – | – | – | – | – | – | – | – |
| Nuclear Periphery | – | – | – | – | – | – | – | – | – | – | – | – | – | – | – | – | – | – |
| Nucleolus | – | – | – | – | – | – | – | – | – | – | – | – | – | – | – | – | – | – |
| Nucleus | – | – | – | – | – | – | – | – | – | – | – | – | – | – | – | – | – | – |
| Peroxisomes | – | – | – | – | – | – | – | – | – | – | – | – | – | – | – | – | – | – |
| Punctate Nuclear | – | – | – | – | – | – | – | – | – | – | – | – | – | – | – | – | – | – |
| Vacuole | – | – | – | – | – | – | – | – | – | – | – | – | – | – | – | – | – | – |
| Vacuole Periphery | – | – | – | – | – | – | – | – | – | – | – | – | – | – | – | – | – | – |
Sequencing Data
| R1 | R2 | |||||||||
|---|---|---|---|---|---|---|---|---|---|---|
| G1 Post-START | S/G2 | Metaphase | Anaphase | Telophase | G1 Post-START | S/G2 | Metaphase | Anaphase | Telophase | |
| Gene Expression | 23.3114 | 16.6711 | 10.9962 | 28.2501 | 18.8062 | 16.5678 | 28.796 | 30.3381 | 30.8477 | 34.5916 |
| Translational Efficiency | 2.3933 | 2.7257 | 4.373 | 1.327 | 2.7338 | 4.2783 | 1.8102 | 1.672 | 1.8441 | 1.8029 |
Hit Data
| Dataset | Hit |
|---|---|
| Protein Concentration | – |
| Protein Localization | – |
| Gene Expression | ✘ |
| Translational Efficiency | ✘ |
Endocytosis
| Temp | Actin Patch (Sac6-tdTomato) | Cortical Patch (Sla1-GFP) | Late Endosome (Snf7-GFP) | Vacuole (Vph1-GFP) |
|---|---|---|---|---|
| 37℃ | ||||
| RT |
Cell Cycle Omics
CYCLoPs (Ure2-GFP)
| Gene / Allele | Actin Patch (Sac6-tdTomato) | Cortical Patch (Sla1-GFP) | Late Endosome (Snf7-GFP) | Vacuole (Sac6-tdTomato) |
|---|
| Gene | Images |
|---|
| Gene | Images |
|---|
Images are not yet available
Images are not yet available